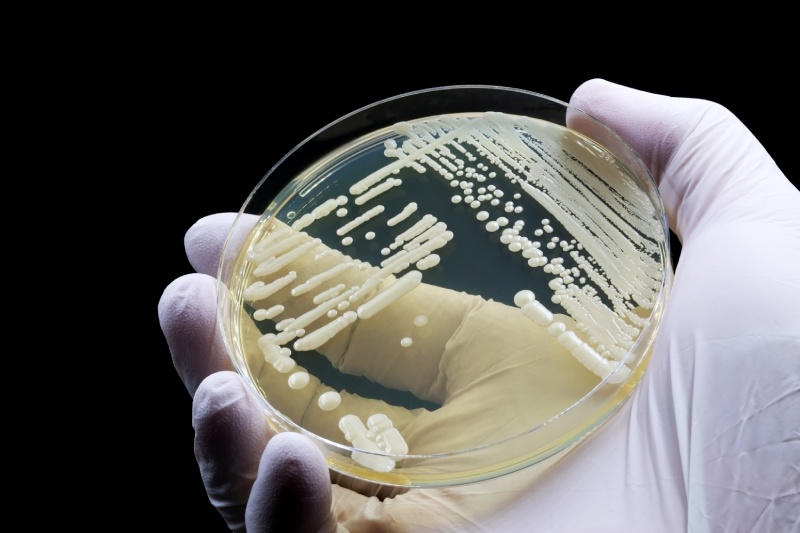
هشدار جهانی درباره قارچ مرگبار مقاوم به دارو: کاندیدا اوریس

هشدار جهانی درباره قارچ مرگبار مقاوم به دارو: کاندیدا اوریس
قارچ های مقاوم به دارو یکی از خطرناک ترین تهدیدات نوظهور سلامت جهانی به شمار می روند و می توانند موجب شیوع بیماری هایی شوند که درمان آنها بسیار دشوار است. کاندیدا اوریس، گونه ای قارچی که برای نخستین...
قارچ های مقاوم به دارو یکی از خطرناک ترین تهدیدات نوظهور سلامت جهانی به شمار می روند و می توانند موجب شیوع بیماری هایی شوند که درمان آنها بسیار دشوار است. کاندیدا اوریس، گونه ای قارچی که برای نخستین بار در سال ۲۰۰۹ شناسایی شد، نمونه برجسته این تهدید است. این قارچ نه تنها سرعت انتشار بالایی دارد، بلکه مقاومت شدید آن در برابر داروهای رایج، نگرانی دانشمندان و پزشکان سراسر جهان را برانگیخته است. این مقاله به بررسی آخرین یافته ها، خطرات و اقدامات پیشگیرانه مربوط به کاندیدا اوریس می پردازد.
کاندیدا اوریس؛ تهدیدی نوظهور برای سلامت جهانی
کاندیدا اوریس یک قارچ فرصت طلب است که در ابتدا تنها به عنوان عامل عفونت های بیمارستانی شناخته می شد. با گذشت زمان، این گونه توانست در محیط های مختلف و در کشورهای متعدد گسترش یابد و اکنون یک تهدید جهانی محسوب می شود.
براساس گزارش های علمی منتشر شده در نشریه Microbiology and Molecular Biology Reviews، از زمان کشف کاندیدا اوریس در گوش یک بیمار در ژاپن، این قارچ به بیش از ۵۰ کشور جهان نفوذ کرده است. در ایالات متحده، بیش از ۴۵۰۰ مورد ابتلا در سال ۲۰۲۳ ثبت شده و این قارچ در ۳۹ ایالت حضور دارد. مشکل اصلی این قارچ، تشخیص دشوار آن است؛ ابزارهای معمول آزمایشگاهی اغلب قادر به تمایز کاندیدا اوریس از گونه های دیگر نیستند و تشخیص دیرهنگام می تواند منجر به مرگ بیمار شود.
علائم، شیوع و نرخ مرگ و میر
کاندیدا اوریس می تواند به مدت طولانی بدون علائم روی پوست انسان زندگی کند، اما در افراد دارای سیستم ایمنی ضعیف، عفونت های جدی ایجاد می کند. این ویژگی، قارچ را به یک تهدید بالقوه مرگبار تبدیل کرده است.
مطالعات نشان می دهند که نرخ مرگ و میر بیماران مبتلا به کاندیدا اوریس بستری در بیمارستان حدود ۳۰ درصد است و در صورت ورود عفونت به جریان خون، این رقم به ۵۰ درصد افزایش می یابد. به طور کلی، عفونت های قارچی سالانه نزدیک به ۴ میلیون نفر را در جهان به کام مرگ می کشانند که نسبت به دهه گذشته تقریبا دو برابر شده است. این ارقام اهمیت مقابله سریع با این قارچ را به وضوح نشان می دهند.
مقاومت دارویی و سویه های پان مقاوم
یکی از مهم ترین دلایل خطرناک بودن کاندیدا اوریس، مقاومت آن در برابر داروهای ضدقارچ رایج است. برخی از سویه های این قارچ به صورت پان مقاوم شناخته شده اند، به این معنا که در برابر چهار کلاس اصلی داروهای ضدقارچ موجود کاملا ایمن هستند.
این مقاومت باعث شده که درمان بیماران بسیار دشوار شود و حتی در برخی موارد گزینه های درمانی محدود به داروهای جدید یا ترکیبی باشد. متخصصان بهداشتی هشدار می دهند که بدون توسعه داروهای جدید و واکسن های پیشگیرانه، کنترل این قارچ در آینده نزدیک دشوار خواهد بود.
تغییرات اقلیمی و ظهور کاندیدا اوریس

یکی از جنبه های پژوهشی جذاب در مورد کاندیدا اوریس، ارتباط احتمالی آن با تغییرات اقلیمی است. برخی پژوهشگران معتقدند که این قارچ ممکن است یکی از نخستین بیماری های قارچی نوظهور ناشی از گرمایش جهانی باشد.
مطالعات نشان می دهند که کاندیدا اوریس توانسته است خود را با دمای محیط های رو به افزایش سازگار کند؛ به گونه ای که دمای بدن انسان برای آن قابل تحمل شده و این ویژگی، زمینه ابتلا انسان ها به عفونت را فراهم کرده است. این یافته ها اهمیت توجه به اثرات تغییرات اقلیمی بر ظهور بیماری های نوظهور را برجسته می کند.
اقدامات درمانی و داروهای جدید
با وجود تهدید بالای کاندیدا اوریس، پژوهشگران و سازمان های بهداشتی جهانی تلاش های گسترده ای برای مقابله با آن آغاز کرده اند. توسعه داروهای جدید و واکسن های پیشگیرانه در دستور کار قرار دارد تا تهدید این قارچ کاهش یابد.
در سال ۲۰۲۳، سازمان غذا و داروی آمریکا (FDA) داروی Rezafungin را برای درمان عفونت های تهاجمی کاندیدا اوریس تأیید کرد. علاوه بر این، چندین داروی امیدوارکننده دیگر در مراحل نهایی آزمایشات بالینی قرار دارند. پیشرفت هایی نیز در زمینه تولید واکسن های عمومی ضدقارچ حاصل شده است که می تواند ایمنی در برابر طیف گسترده ای از پاتوژن های قارچی ایجاد کند.
نقش تشخیص سریع و پیشگیری
تشخیص سریع و دقیق کاندیدا اوریس از اهمیت حیاتی برخوردار است. ابزارهای تشخیصی پیشرفته و روش های مولکولی می توانند به کاهش میزان مرگ و میر و جلوگیری از گسترش قارچ کمک کنند.
با بهبود تست های آزمایشگاهی و آموزش کادر پزشکی، شناسایی به موقع بیماران امکان پذیر می شود. علاوه بر این، اقدامات بهداشتی مانند رعایت بهداشت بیمارستانی، ضدعفونی تجهیزات و کنترل ورود و خروج بیماران در جلوگیری از شیوع این قارچ نقش اساسی دارد.
چشم انداز آینده و تحقیقات علمی
محققان به دنبال درک بهتر مکانیسم های مولکولی کاندیدا اوریس هستند تا درمان های مؤثر و استراتژی های پیشگیرانه جدید طراحی کنند. شناخت ژنتیک، مسیرهای متابولیک و عوامل مقاومت این قارچ می تواند کلید مقابله با شیوع جهانی آن باشد.
پروفسور نیراج چوهان و همکارانش در حال بررسی روش های نوین واکسیناسیون و داروهای ترکیبی هستند تا پیش از آنکه این قارچ به یک بحران جهانی تبدیل شود، نقاط ضعف آن شناسایی و کنترل گردد. این اقدامات علمی، اهمیت تحقیق و توسعه در زمینه پاتوژن های مقاوم به دارو را به خوبی نشان می دهد.
نتیجه گیری
کاندیدا اوریس نمونه ای هشداردهنده از تهدیدات قارچی نوظهور است که می تواند سلامت میلیون ها نفر در سراسر جهان را به خطر بیندازد. مقاومت دارویی، انتشار سریع، و قابلیت بروز عفونت شدید در افراد با سیستم ایمنی ضعیف، آن را به یکی از خطرناک ترین پاتوژن های انسانی تبدیل کرده است.
با ادامه تلاش های علمی در زمینه داروهای جدید، واکسن ها و بهبود روش های تشخیصی، امکان کنترل و کاهش شیوع این قارچ وجود دارد. اما این بحران نشان می دهد که جهان باید با جدیت بیشتری به تهدیدات ناشی از بیماری های نوظهور و تأثیر تغییرات اقلیمی بر سلامت انسان توجه کند. کاندیدا اوریس، زنگ خطری برای سلامت جهانی و یادآوری اهمیت پیشگیری و پژوهش علمی است.